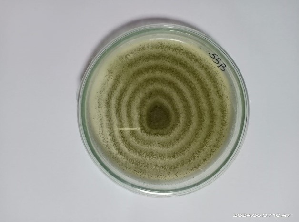
ICAR-IIOPR Unveils Eco-Friendly Biocontrol Breakthrough for Whitefly Management

An entomopathogenic fungi, Aspergillus sp. R55 as biocontrol agent for management of rugose spiralling whitefly
Rugose spiraling whitefly (RSW), AleurodicusrugioperculatusMartin (Hemiptera: Sternorrhyncha: Aleyrodidae) was established as a potential pest of oil palm in India since its introduction as invasive whitefly species during 2016. The aggressive distribution and damage potential of the pest necessitated inevitable interventions of pest management.
However, due to alien nature, application of chemical pesticides is constrained in order to support the activity of native natural enemies. At this juncture, an effective, ecofriendly and sustainable pest management can be attained only by the use of entomopathogens. Keeping this in view, exploration of native entomopathogens against RSW in oil palm ecosystem was attempted using a modified insect baiting technique. This effort led to identification of a potent entomopathogenic fungi, R55 against RSW. Under laboratory conditions, the isolate was found to be highly pathogenic against adult stages of RSW with a mortality of cent percent at 106 conidia/ml concentration.
In semi-field evaluation at a concentration of 5ml/L, R55 gave a pest reduction of 94.74 over control. In a two-year field evaluation, the isolate also performed consistently well with a pest reduction of 91% and 98.67% during 2022 and 2023, respectively. Under favourable environmental conditions like high RH, the isolate was able cause epizootics in adults of RSW. The isolate also showed substantial production of conidia (109 conidia/ml) with temperature tolerance with more than 50% survival of conidia after exposure to 50ºC for one hour. Most importantly, the isolate is highly amicable to two-pronged mass production technology developed by ICAR-IIOPR, Pedavegi.

Potential impact of the research finding
The biocontrol agent R55 was already popularized amongst the oil palm farming community of Eluru, East and west Godavari districts of Andhra Pradesh. Till date, 39 liters of Aspergillus sp. R55, was produced and given to a total of 44 farmers with reported successful reduction in the pest population. This quantum of R55 caters management of rugose spiraling whitefly in 1014 ha area of oil palm.
(Source: ICAR-Indian Institute of Oil Palm Research, Pedavegi, Andhra Pradesh)








Like on Facebook
Subscribe on Youtube
Follow on X X
Like on instagram